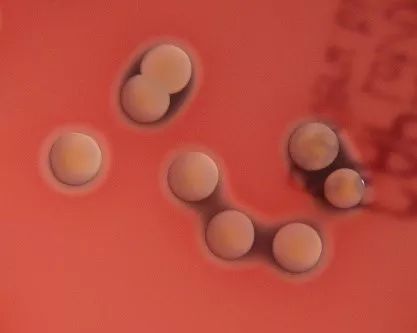
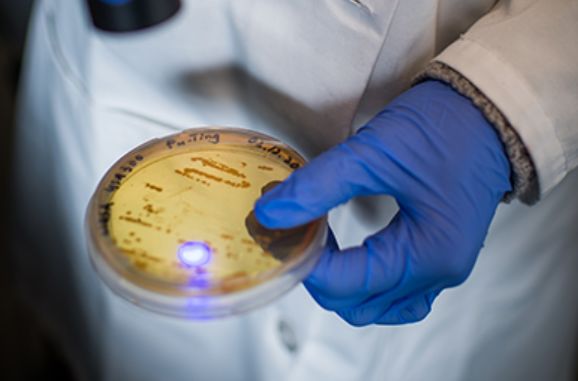

|
金色的“葡萄”会致病,不如给它漂个白?科普中国-我是科学家 2019-07-23 |
作者:Nekout
编辑:Yuki
葡萄应该是大家最熟悉的水果了。你或许品尝红色、白色、紫色、绿色的葡萄,每一颗都晶莹剔透又酸甜可口。

不同颜色的葡萄串|solomonitg-com
不过,有这样一种金灿灿的“葡萄串”却并不可口,不小心吃下去还可能给我们的健康带来不良影响。
它就是大名鼎鼎的金黄色葡萄球菌。
自带“黄金甲”的“葡萄串”
19世纪80年代,一位名叫亚历山大·奥古斯通(Alexander Ogston)的英国医生,从病人的脓肿中常常分离得到一种形似葡萄串的球菌,这种细菌在含有动物血液的琼脂平板上能形成金黄色的菌落。
血平板上的金黄色葡萄球菌 | Wikimedia Commons
之后,德国微生物学家弗里德里希·朱利斯·罗森巴赫(Friedrich Julius Rosenbach)将其命名为Staphylococcus aureus(金黄色葡萄球菌),其中Staphylococcus来源于希腊文,意为“葡萄串”,aureus则来自于拉丁文,意为“金黄色的”。

电镜照下的“金葡萄” | CDC
金黄色葡萄球菌之所以呈现出鲜亮的金黄色,是因为它能合成一种名为“葡萄球菌黄素”(Staphyloxanthin)的类胡萝卜素色素,它大概长下面这个样子。

葡萄球菌黄素(Staphyloxanthin)| Wikimedia Commons
葡萄球菌黄素长长的疏水性碳链,使其可以嵌入金黄色葡萄球菌的细胞膜上。而葡萄球菌黄素与其他类胡萝卜素一样,都具有抗氧化的作用,能抵抗宿主免疫细胞分泌的具有杀菌能力的各种类型活性氧。因此,金黄色葡萄球菌可谓自带“黄金甲”神装。

各种类型的活性氧 | vivo.colostate.edu
金色的“葡萄”危害广
金黄色葡萄球菌导致的疾病种类跨度之广,侵染宿主范围之大,感染比例之高在微生物界可谓翘楚。
人群中每三个人中就有一个是金黄色葡萄球菌的长期携带者。它们通常寄宿在人体上温暖潮湿的地方,如鼻腔黏膜、腋下以及腹股沟处。平时它们静静潜伏,当宿主的皮肤或粘膜受损时,它们就会入侵宿主惹事生非。
它能导致的疾病也多种多样,轻度的如常见的皮肤、粘膜的感染,这时几元钱的外用抗生素软膏就能将它们轻松消灭;若吃下了金黄色葡萄球菌污染的食物,尽管烹饪时的高温会尽数杀死它,然而它留下的遗产——肠毒素,却会让你驻足马桶,用尽抽纸。

金黄色葡萄球菌产生的肠毒素会让你驻足马桶不能自已 | positivelyaware
重度的感染疾病则十分凶险,在抗生素被应用于临床前,金黄色葡萄球菌导致的肺炎死亡率高达30%,然而它还并不会止步于此,它还能导致心内膜炎、菌血症、中毒性休克征等高死亡率的疾病。
据美国疾控中心的统计,每年仅美国就有8万余人严重感染金黄色葡萄球菌,并最终造成其中约1万人死亡。

2013年美国疾控中心对甲氧西林抗性金黄色葡萄球菌的致病统计结果 | USCDC
除了感染人类外,其他哺乳动物也都是他的猎物。特别是人类集中饲养的经济动物更深受其害。在奶牛身上,金黄色葡萄球菌会导致乳腺炎,显著降低牛奶的产量和质量;在家禽上,它能导致足垫炎和关节炎,直白的说,你爱啃的鸡爪正好金黄色葡萄球菌也爱啃。

被金黄色葡萄球菌“啃”过的鸡爪 | poultrydvm
无法将我置于死地的,更令我坚强
自20世纪40年代,人类发现的第一种抗生素——青霉素开始在临床中用于治疗感染疾病,许多肆虐数世纪的传染病都或被控制或消灭,人类的平均寿命自此也有了显著的提升。

青霉素发现者:亚历山大·弗莱明(Alexander Fleming)| Wikimedia Commons
然而,致病菌也随即发起反抗。金黄色葡萄球菌率先扛起了耐受抗生素的大旗——几乎与抗生素应用于临床同时,医院中就发现了耐受青霉素的金黄色葡萄球菌。
不仅如此,金黄色葡萄球菌还会慷慨地将耐抗生素的基因传递给其他同类或不同类的细菌。时至今日,在医院中分离得到的金黄色葡萄球菌中超过90%都具有青霉素的耐受性,而其他细菌的青霉素耐受性亦十分普遍。这也是为何现在医院中已很少使用青霉素的一个重要原因。

细菌通过发朋友圈基因水平转移来共享耐药基因 | Yuki小柒
自青霉素之后,人类开发了数千种或在临床或在畜牧生产中使用的抗生素,然而细菌也没闲着,在一种新抗生素应用一段时间后,我们总能发现携带了新抗生素耐受基因的细菌。就连抗生素中的终极大招—万古霉素、达托霉素、利奈唑胺也已不能保证能100%杀死所有的金黄色葡萄球菌。
另辟蹊径:用CRISPR来杀菌
为了防止未来“无药可用”的现象发生,人们开始另辟蹊径来对付耐药菌。
CRISPR技术在当下可谓基因编辑领域的当红宠儿。CRISPR系统是来自于细菌的一套免疫系统,用来切断外源入侵细菌的噬菌体或质粒或其他DNA片段,保护自身DNA的完整。但若人为设计一段具有自靶向能力的CRISPR RNA转入细菌中,细菌便会敌我不分,切断自己的基因组DNA。

CRISPR-Cas9的原理示意图 | jhu
在真核生物细胞中进行基因编辑时,通过CRISPR RNA的引导,Cas蛋白能够切断DNA,当不提供用于修复断裂的供体DNA时,真核生物细胞中有一套应急的DNA修复机制,称为非同源末端重组(Non-homologous end joining, NHEJ),能够快速将断裂处修复。然而,绝大部分的细菌并没有像真核细胞一样具有非同源末端重组的快速应急修复系统,断掉的DNA不能自己连起来,细菌也就因此死掉了。
用CRISPR系统杀菌的最大优势是可以“定向打击”,人们可以根据病原菌的特异性基因设计只杀病原菌的武器,而不会误伤对人有益的其他共生细菌。这就避免了抗生素那种“无差别轰炸”的模式,保护了人体内的共生菌。
“黄金甲”太强,不如给它漂个白?
前面说过,葡萄球菌黄素具有抗氧化的作用,能抵抗宿主各类活性氧防御。那么,如果想办法去掉这层“黄金甲”,会发生什么呢?近期发表在《尖端科学》(Advanced Science)杂志上的一项研究显示,给“金葡萄”漂白后,它们会明显变弱。
波士顿大学的研究团队正在对金黄色葡萄球菌进行“漂白”处理 | BU
这组来自波士顿大学的研究团队对金黄色葡萄球菌进行显微观察时,发现使用特定波长(450-470nm)的蓝光照射金黄色葡萄球菌时会发生光漂白现象。而这种光漂白现象的出现意味着葡萄球菌黄素的降解。


蓝光使葡萄球菌黄素降解 | 参考文献1
研究者们后来发现,这种蓝光不仅可以降解金黄色葡萄球菌细胞膜上的葡萄球菌黄素,让它们丢掉“黄金甲”,还会在细胞膜上留下临时的孔洞,使其在短时间内“门户大开”。
丢盔卸甲的金黄色葡萄球菌,不再“百药不侵”,这时若配合过氧化氢,则能够比抗生素更加有效地杀死它们。研究者们已经通过试验证明,这种漂白+趁虚而入的方法可以杀死99.9%的耐甲氧西林金黄色葡萄球菌(MRSA),还能够加速感染MRSA小鼠皮肤伤口的愈合。
这项研究为治疗抗药性金黄色葡萄球菌导致的感染疾病,提供了一种崭新的手段,它只对葡萄球菌黄素奏效,不容易让细菌产生耐受性,治疗过程也不会给患者造成创伤。论文作者Jie Hui表示:“这种激光照射不会给人体带来痛觉,非常适合临床应用。”

研究者们正在努力将蓝光疗法转化为临床,希望它可以帮助治疗糖尿病溃疡患者 | BU
只要这些金色的“葡萄”还在威胁人们的健康,科学家与它们的较量就不会停步。或许有一天,它们将不得不抛弃金灿灿的大名,做回一串人畜无害的普通“葡萄”。

作者名片

排版:陈小砖
题图来源:CDC
参考文献:
1. Dong P T, Mohammad H, Hui J, et al. Photolysis of Staphyloxanthin in Methicillin‐Resistant Staphylococcus aureus Potentiates Killing by Reactive Oxygen Species[J]. Advanced Science, 2019: 1900030.
责任编辑:王超
上一篇:中美科学家揭秘西班牙神秘鸟足迹
下一篇:蚊子怎么会“盯”上你?
科普中国APP
科普中国微信
科普中国微博

最新文章
-
为何太阳系所有行星都在同一平面上旋转?
新浪科技 2021-09-29
-
我国学者揭示早期宇宙星际间重元素起源之谜
中国科学报 2021-09-29
-
比“胖五”更能扛!我国新一代载人运载火箭要来了
科技日报 2021-09-29
-
5G演进已开始,6G研究正进行
光明日报 2021-09-28
-
“早期暗能量”或让宇宙年轻10亿岁
科技日报 2021-09-28
-
5G、大数据、人工智能,看看现代交通的创新元素
新华网 2021-09-28








